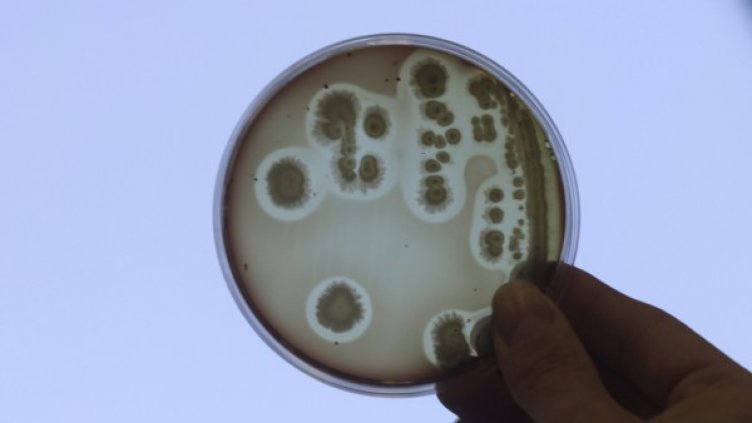
Снимка: Reuters, архив

Наши и японски учени са открили случайно безценна бактерия, която може да промени световната медицина. Тя се нарича лептотрикс и се твърди, че е по-ценна от златото. Неин продукт се използва за създаването на биочипове.
"Още сме съвсем в началото, но ако успеем да създадем биочип, той ще може при имплантация да възстанови зрението или да вдигне на крака инвалид с прекъснати нервни връзки на гръбначния стълб", обясниха пред "Телеграф" учени от Института по електроника към БАН и Биологичния факултет на Софийския университет.
Бактерията намира приложение и при ранна диагностика на ракови заболявания с ядрено-магнитен резонанс. Освен това произвежда пигменти, които могат да се използват за производство на биогрим за дамите и помага за откриване на тежки метали в замърсената вода.
Бактерията е открита съвсем случайно в близост до хижа "Алеко" на Витоша, разказва проф. д-р на техн. науки Иван Недков от Института по електроника.
Още през 2005 г. институтът обменя опит с японски учени. При една от срещите българските учени предлагат да се разходят до Витоша. Там един от японските учени, изучавал дълго време въпросната бактерия, я открил в планинските потоци.
Лептотрикс е невидима за човешкото око, но произвежда нанотръбички, които, когато се наслоят, създават типично червеникава утайка върху чешмата или водата в потоците. По този начин японецът я намерил на Витоша. Тя обича да се възпроизвежда в чисти водоеми.
Потоците с "вълшебната вода" са добре познати на туристите, които обичат да се разхождат на Витоша. Хората от години се възползват от лековитите свойства на водата и често лекуват своите болежки именно по този начин.
Това се случи Dnes, за важното през деня ни последвайте и в Google News Showcase.

Търговията със злато не е същата като отпреди 10 години
Търговията със злато не е същата като отпреди 10 години  Банките в Европа могат да увеличат кредитирането с над 2 трлн. евро, ако се опростят регулациите
Банките в Европа могат да увеличат кредитирането с над 2 трлн. евро, ако се опростят регулациите  Фискалният съвет препоръча свиване на разходите за болнична помощ
Фискалният съвет препоръча свиване на разходите за болнична помощ  Калоян Тончев: Фокусът на финтех компаниите е върху инфраструктурата на утрешните пари
Калоян Тончев: Фокусът на финтех компаниите е върху инфраструктурата на утрешните пари  Mercedes търси контрол върху разходите с AI и предоговаряне на условията със синдикатите
Mercedes търси контрол върху разходите с AI и предоговаряне на условията със синдикатите  ЕК одобри четвъртото плащане за България по Плана за възстановяване и устойчивост
ЕК одобри четвъртото плащане за България по Плана за възстановяване и устойчивост 
 Осъдиха Симона Радева на 3,6 години затвор за укриването на Семерджиев
Осъдиха Симона Радева на 3,6 години затвор за укриването на Семерджиев  Голям пожар в Слънчев бряг, гъст дим изплаши туристите
Голям пожар в Слънчев бряг, гъст дим изплаши туристите  ДПС поиска НСО да съобщи каква охрана са имали Пеевски и други лица от 2013 г.
ДПС поиска НСО да съобщи каква охрана са имали Пеевски и други лица от 2013 г.  Военният министър: САЩ искат военните самолети да останат на летището в София до 30 юли
Военният министър: САЩ искат военните самолети да останат на летището в София до 30 юли  Почина обвиняем по делото за трагедията в Кочани
Почина обвиняем по делото за трагедията в Кочани  Пеканов: България ще получи близо 1 млрд. евро по четвъртото плащане по ПВУ
Пеканов: България ще получи близо 1 млрд. евро по четвъртото плащане по ПВУ 
 Петев похвали двама от Босна и Херцеговина
Петев похвали двама от Босна и Херцеговина  Анчелоти обясни защо перла на Бразилия не играе на Мондиала
Анчелоти обясни защо перла на Бразилия не играе на Мондиала  Цварц тренира с ЦСКА, вижте как го посрещнаха + СНИМКИ
Цварц тренира с ЦСКА, вижте как го посрещнаха + СНИМКИ  Жоел Цварц пристигна в Австрия и се присъедини към лагера на ЦСКА
Жоел Цварц пристигна в Австрия и се присъедини към лагера на ЦСКА  ЦСКА ще се бори за титлата, но до две години
ЦСКА ще се бори за титлата, но до две години  Мачовете по телевизията днес, 19 юни
Мачовете по телевизията днес, 19 юни 
 10 плажни маникюра, с които ще впечатлите всички
10 плажни маникюра, с които ще впечатлите всички  Таро карти за юли за всяка зодия
Таро карти за юли за всяка зодия  10 рецепти за лятното слънцестоене на 21 юни
10 рецепти за лятното слънцестоене на 21 юни  Как да организираме перфектното работно място у дома за максимална концентрация?
Как да организираме перфектното работно място у дома за максимална концентрация?  Често допускани грешки при завеждане на щета – как да не загубим обезщетението си?
Често допускани грешки при завеждане на щета – как да не загубим обезщетението си?  Психологът Михаела Георгиева: При атичифобия човек непрекъснато отлага и не започва нови неща
Психологът Михаела Георгиева: При атичифобия човек непрекъснато отлага и не започва нови неща 
 продава, Тристаен апартамент, 92 m2 София, Изгрев, 380000 EUR
продава, Тристаен апартамент, 92 m2 София, Изгрев, 380000 EUR  продава, Четиристаен апартамент, 170 m2 София, Манастирски ливади Запад, 401000 EUR
продава, Четиристаен апартамент, 170 m2 София, Манастирски ливади Запад, 401000 EUR  продава, Двустаен апартамент, 78 m2 София, Малинова Долина, 175000 EUR
продава, Двустаен апартамент, 78 m2 София, Малинова Долина, 175000 EUR  продава, Двустаен апартамент, 65 m2 София, Надежда 3, 152000 EUR
продава, Двустаен апартамент, 65 m2 София, Надежда 3, 152000 EUR  продава, Магазин, 33 m2 София, Красно Село, 130000 EUR
продава, Магазин, 33 m2 София, Красно Село, 130000 EUR  продава, Офис, 37 m2 София, Дианабад, 75000 EUR
продава, Офис, 37 m2 София, Дианабад, 75000 EUR 
 Засилват контрола върху чистотата на морската вода и плажовете във Варненско
Засилват контрола върху чистотата на морската вода и плажовете във Варненско  Варненски ученици дискутираха върху идеите на Апостола с проф. д-р Даниел Вълчев и експерти
Варненски ученици дискутираха върху идеите на Апостола с проф. д-р Даниел Вълчев и експерти  ЕК даде зелена светлина за четвъртото ни искане за плащане по Плана за възстановяване и устойчивост
ЕК даде зелена светлина за четвъртото ни искане за плащане по Плана за възстановяване и устойчивост  Затвориха за граждани басейн „Юлиан Русев“ към ПК „Приморски“ във Варна
Затвориха за граждани басейн „Юлиан Русев“ към ПК „Приморски“ във Варна  Започна ежегодният учебен сбор по отбранително-мобилизационна подготовка във Варна
Започна ежегодният учебен сбор по отбранително-мобилизационна подготовка във Варна  РЗИ: Морето край варненски плаж гъмжи от Ешерихия коли и Чревни ентерококи
РЗИ: Морето край варненски плаж гъмжи от Ешерихия коли и Чревни ентерококи 
 НАСА разширява партньорството си с частния сектор за сателитни данни
НАСА разширява партньорството си с частния сектор за сателитни данни  Европейските космически оператори се споразумяха за нови правила за безопасност в орбита
Европейските космически оператори се споразумяха за нови правила за безопасност в орбита  В марсиански метеорит откриха камък, какъвто не се среща на Червената планета
В марсиански метеорит откриха камък, какъвто не се среща на Червената планета  ЕКА изстреля нова конфигурация на „Ариана 6“ с рекорден товар
ЕКА изстреля нова конфигурация на „Ариана 6“ с рекорден товар  Защо бедните остаряват по-бързо от богатите: Проучване разкрива причините
Защо бедните остаряват по-бързо от богатите: Проучване разкрива причините  Създадоха невроморфен чип, който имитира човешкото зрение
Създадоха невроморфен чип, който имитира човешкото зрение 












